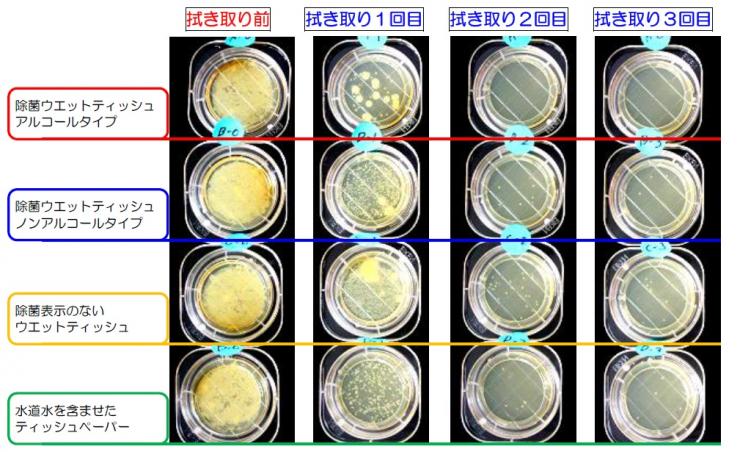

販促用のウェットティッシュ・オリジナルウェットティッシュならウェットティッシュ本舗へ
受付時間 9:00~18:00(土日祝を除く)
除菌アルコールウェットティッシュ(国産)
- 印刷不可

ウィルス対策グッズとして大人気の除菌アルコールウェットティッシュ!
外出先でハンドジェルやアルコール消毒液がなくても安心です。
会社や外出先で使いやすいから喜ばれること間違いなし。
風邪やインフルエンザなど、感染症に注意が必要な冬場は重宝するでしょう。
高い受取率が期待できますし、なんと即日発送OK!
ノベルティ・販促品で会社の知名度を上げたい方、早く商品がほしい方におすすめしたい商品です。
ただし、数に限りがございますのでお早めに!
1個あたり46.2円~(税込)
商品のみ5000個の場合
ご注文いただけない選択肢です。選択肢を変更してください
この商品の目安納期
オプションの内容や校正状況などにより納期は変動いたします。上記は目安となりますのでご了承ください。目安よりも早くお届けが可能な場合もありますのでお気軽にご相談ください。
御見積
商品代金
-
入稿費用
-
送料
-
¥ --
税込み合計
消費税の計算上、ご購入の際に合計額が異なる場合があります
除菌アルコールウェットティッシュ(国産)の詳細
パッケージ色
白
入り枚数
10枚
寸法
(外袋)145mm×85mm、(原紙)140mm×200mm
最低ロット
(商品のみ)500個~
送料
関東~九州まで1ヶ所3ケース(1500個)以上元払い。
差額送料
東北400円/ケース・北海道500円/ケース ※1ヶ所2ケース以下は600円/1ヶ所
管理コード:328
アルコールウェットティッシュで除菌しましょう!
今年猛威をふるっている新型コロナウィルス、インフルエンザなど、ウィルスは毎年問題になりますよね。
アルコールウェットティッシュで除菌して、身の回りを清潔に保ちましょう。
除菌アルコールウェットティッシュで本当に菌が減るの?
「アルコール入りでもウェットティッシュに除菌効果なんてあるの?」という疑問をお持ちの方!
埼玉県が実施した除菌ウェットティッシュに関するテストでは、次のような結果が出ています。
写真.ウエットティッシュの拭き取り回数と除菌効果(白い点が菌)
- アルコールタイプ、ノンアルコールタイプのいずれの除菌ウエットティッシュも、1回の拭き取りだけで全ての細菌を除去することは困難でした。
- 除菌ウエットティッシュ(アルコールタイプ)が最も除菌効果がありましたが、除菌表示のないウエットティッシュや水道水を含ませたティッシュペーパーでも除菌をすることができました。
- いずれのテスト対象商品も拭き取りの回数を重ねることで細菌数を減少させ、3回目の拭き取り後は大部分の細菌を除去することができました。
テスト結果によると、3回目の拭き取り後は大部分の菌を除去できたということです。
また、4種類の中ではアルコールタイプのウェットティッシュに最も除菌効果があったことも分かっています。
会社内や店舗内を清潔にしておけば、従業員だけでなくお客さんも安心です!
アルコールウェットティッシュをぜひご活用ください。
除菌アルコールウェットティッシュでの除菌方法
除菌アルコールウェットティッシュを使う時は、次の2点に注意が必要です。
- 拭く場所
- 拭き方
ここからは、アルコールウェットティッシュを使ったおすすめの除菌方法をご紹介します。
ドアノブやキーボードなどよく触る場所を拭く
除菌アルコールウェットティッシュを使うなら、人の手がよく触れる場所を重点的に拭きましょう。
【会社の場合】
- ドアノブ
- パソコンのキーボード
- プリンター
など
【店舗の場合】
- ドアノブ
- メニュー表
- お客さんが読む雑誌類
など
折りたたんで3回の使用が経済的
1度使ったウェットティッシュを繰り返し使うと、ウェットティッシュに付いた菌が他の場所に付着するかもしれません。
ウェットティッシュ1枚を有効活用するには、次の方法がおすすめです。
- 半分に折りたたんで1回目の拭き取り
- 使っていない面で2回目の拭き取り
- 裏返して3回目の拭き取り
ウェットティッシュでの除菌についてよくある質問
ウェットティッシュでの除菌に関して、よくある質問をまとめてみました。
どんな成分が入ってるの?効果は?
当店の除菌アルコールウェットティッシュに入っている成分、成分の特徴は次の通りです。
4種類ある成分の内、エタノールと塩化ベンザルコニウムに除菌作用が期待できます。
- 精製水
精製水とは、ミネラルや細菌をろ過した水のことです。 不純物が入っておらず肌の負担にならないため、化粧水など美容関連の商品によく使われます。 - エタノール(アルコール)
エタノールはアルコールの一種で、除菌作用を持つ成分です。
濃度70%以上で高い効果を発揮しますが、40%以下でも繰り返し使用すると殺菌力が認められると報告されています。
※当商品のエタノール濃度は30%です。
参考サイト:食品工場の微生物制御へのアルコールの利用技術 (2012年7月発行) - バラペン
パラベンはパラオキシ安息香酸エステルの総称で、防腐剤としておなじみです。
毒性が低いため、化粧品など幅広い分野で使われています。 - 塩化ベンザルコニウム
塩化ベンザルコニウムは抗菌や洗浄に使われる成分です。
手や指の消毒に適しているとされ、消毒薬として広く使われています。
参考サイト:健栄製薬 | 9.塩化ベンザルコニウム 塩化ベンゼトニウム|各種消毒薬の特徴 | 感染対策・手洗い (参照 2020-04-09)
人が触りそうな場所・モノは全部拭いた方がいい?
人が触りそうな場所やモノを「全部拭く」除菌方法は、キリがないのでおすすめできません。
人がよく触る場所やモノは拭いて、手洗いをこまめに行う方が現実的です。
アルコールウェットティッシュでスマホを拭いても変色・変形しない?
アルコール入りグッズによるスマホの除菌は、変色や変形の恐れがあるためNGとされていました。
しかし、近年は各メーカーとも少しずつ見解を変えており、基本的にアルコールウェットティッシュでやさしく拭く程度であれば許容されるようです。
各メーカーの見解については、次のページをご覧ください。
ご注文から納品までの流れ
ご注文
データ作成・入稿
メールや転送サービスにて入稿
校正
弊社より校正メールのご返信
お客様確認・ご入金
印刷手配・納品
デザインデータの作成について
よくあるご質問
納期はどのくらいかかりますか?
オリジナルウェットティッシュ データ校了後、約2週間~4週間(繁忙期には納期がかかりますのでご注意下さい)
商品のみ 翌営業日~1週間以内(繁忙期には納期がかかる場合がありますのであらかじめご確認下さい)
カード決済・コンビニ決済は可能ですか?
可能です。
ご希望の商品にご用意させていただいているショッピングカートをご利用ください。
ショッピングカートが無い場合やその他、ご不明な点は
スタッフまでお問い合わせください。
見積は無料で依頼できますか?
はい、可能です。
通常のウェットティッシュフラップ印刷のお見積りから、特殊な仕様のウェットティッシュのお見積まで
対応させていただきます。
お気軽にご相談ください。









